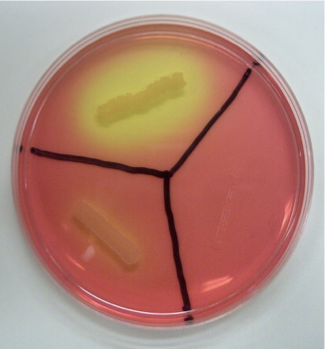
<p>given the picture, give me the interpretations</p>
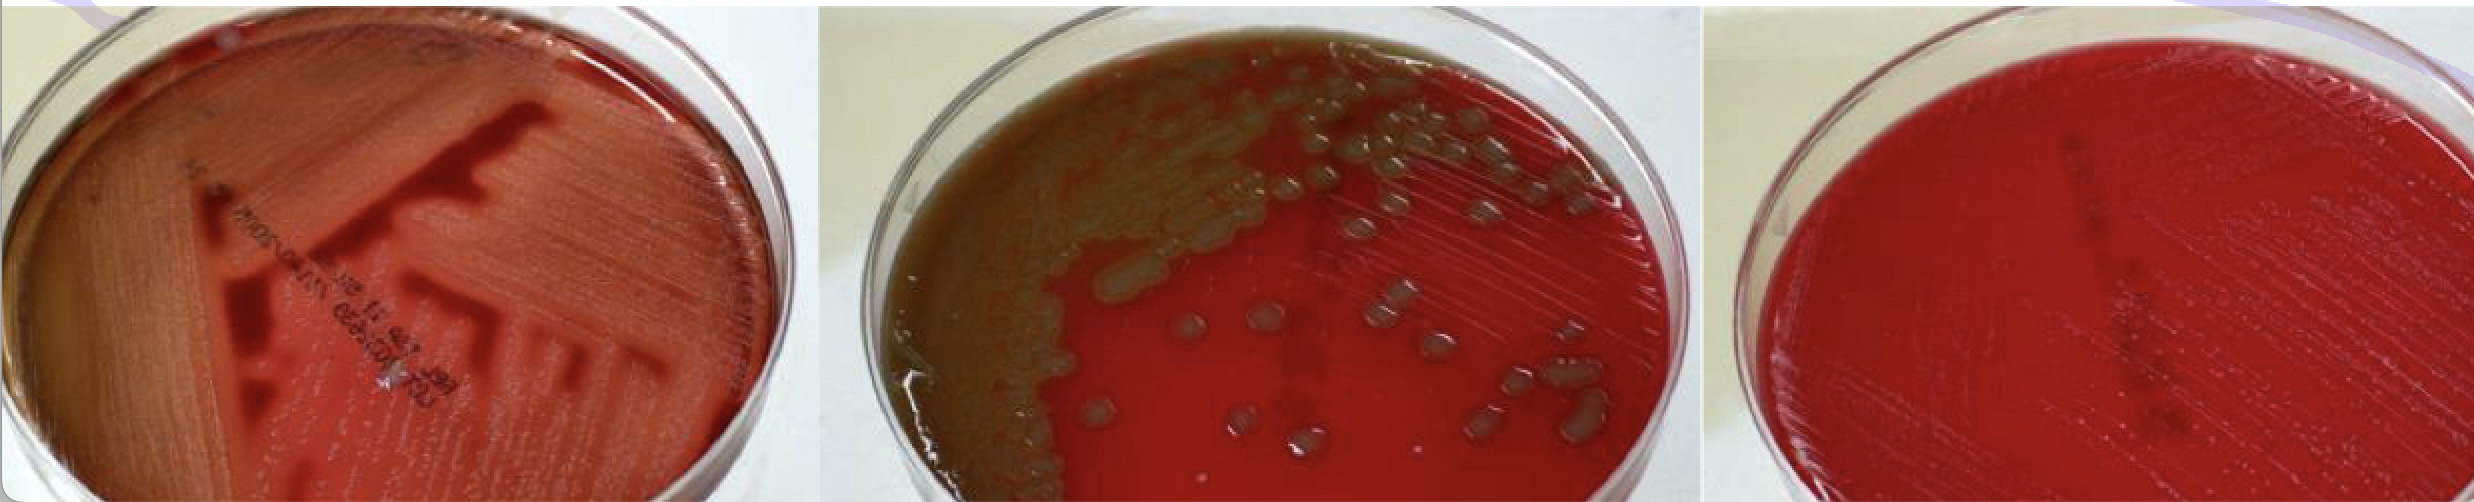
<p>label them </p>

1/161
Looks like no tags are added yet.
Name | Mastery | Learn | Test | Matching | Spaced | Call with Kai |
|---|
No analytics yet
Send a link to your students to track their progress
list the nutritional needs of microbial cells
carbon
nitrogen
nonmetallic elements
metallic elements
vitamins
water
energy
the most essential and central atom common to all cellular structures and functions
carbon
carbon
the most essential and central atom common to all cellular structures and functions (carbohydrates- glucose or lactose)
what are the two carbon-dependent types of microbial cells
autotrophs and heterotrophs
organisms that can be cultivated in medium consisting of solely inorganic compounds; they use inorganic carbon in the form of CO2
autotrophs
autotrophs
category
define
one of the two types of carbon dependent types of microbial organisms
organisms that can be cultivated in medium consisting of solely inorganic compounds; they use inorganic carbon in the form of CO2
organisms that cannot be cultivated in a medium consisting solely of inorganic compounds; they must be supplied with organic nutrients, primarily glucose
heterotrophs
heterotrophs
category
define
one of the two types of carbon dependent types of microbial organisms
organisms that cannot be cultivated in a medium consisting solely of inorganic compounds; they must be supplied with organic nutrients, primarily glucose
an essential atom in many cellular macromolecules, particularly proteins and nucleic acids
nitrogen
what are the major nonmetallic ions used for cellular nutrition
sulfur, phosphorous
sulfur and phosphorus
the major nonmetallic ions used for cellular nutrition
integral to some amino acids, and a component of some proteins; sources include organic compounds such as —- containing amino acids, inorganic compounds, such as sulfates, and elementary—-
sulfur
necessary for the formation of the nucleic acids and for synthesis of high-energy organic compound adenosine triphosphate (ATP) also supplied in salt form
phosphorous
give some metallic elements
CA2+, Zn2+, Na+, K+, CU 2+, Mn 2+, Mg 2+, Fe 2+, Fe 3+
necessary for efficient performance of varied cellular activities such as osmoregulation, regulation of enzyme activity, and electron transport during bio-oxidation. Micronutrients and required in trace concentrations only; inorganic salts d
metallic elements
organic substances contribute to cellular growth and are essential in minute concentration for cell activities. Also sources of co-enzymes, which are required for the formation of active enzyme systems. Some microbes require these to be supplied in a performative state for normal metabolic activities. Some possess extensive synthesizing pathways, whereas others can synthesize only a limited number from the other compounds present in the medium.
vitamins
all cells require this in the medium so that lower molecular weight nutrients can cross the membrane
water
why is water a nutritional need
all cells require water in the medium so that lower molecular weight nutrients can cross the membrane
active transport, biosynthesis, and biodegredation of macromolecules are the metabolic actives of cellular life. These activities can be sustained only if there is a constant availability of within the cell
energy
use radiant energy as their sole energy source
phototrophs
chemotrophs
depend on the oxidation of chemical compounds as their energy source, use organic compounds like glucose, or inorganic compounds like H2S or NaNO2
what are the abiotic/physical factors that influence microbial growth?
temperature
pH
gaseous requirement / atmospheric oxygen
explain how temperature affects the growth and survival of cells
influences the rate of chemical reactions
low temp= slow/inhibits enzyme activity, inhibiting metabolism and cell growth
high temp= coagulation and can irreversibly denature thermolabile enzymes
enzymes differ in terms of heat sensitivity, but generally anything in the range of 70C will destroy bacterial enzymes—> cell death
explain how pH affects the growth and survival of cells
effects cells enzymatic activities
optimal pH = 7
increase in H+ ions= lower pH= more acidic pH
decrease in H+ ions = higher pH= more alkaline conditions
an increase, or decrease in pH= detrimental; will slow down rate of chemical reactions due to destruction of cellular enzymes
explain how atmospheric oxygen/gaseous requirement affects the growth and survival of cells
most cells need atmospheric oxygen for respiration. Atmospheric oxygen—> ATP formation and the availability of energy in a utilizable form form for cell activities; some cell types lack the enzyme systems for respiration in the presence of oxygen, so they have to use an anaerobic form of respiration or fermentation
How do you name a bacteria/ microorganism?
First letter of genus= capitalized, entire name of species (lowercase) follows
Composition
The composition of a growth medium can vary greatly depending on the organisms that will be grown on it. Medium is generally categorized as either defined or complex
Gram positive microorganisms (6)
S. aureus
S. epidermidis
E. faecalis
B. stearothermophilus
C. sporogenes
M. Luteus
Gram negative bacteria (5)
E. coli
K. aerogenes
P. aeruginosa
S. marcescens
P. fluroescenes
Fungi (2)
Saccharomyces cerevisiae
Aspergillus niger
Bacterial growth rate phases (4)
lag phase, log phase, stationary phase, death phase
lag phase of bacterial growth
bacteria adapt themselves to new growth conditions; where the synthesis of RNA, enzymes, and other molecules begin
log phase of bacterial growth rate
characterized by cell doubling at a constant rate (exponential phase)
stationary phase of bacterial growth rate
bacteria stop growing, often due to nutrient limitation; growth and death rate are roughly equivalent
death phase of bacterial growth rate
bacteria die, usually due to adverse conditions; aka decline phase
metabolism
the sum of biochemical reactions required for the generation of energy and the utilization of energy and the utilization of energy to produce cellular components
metabolism
during active growth, bacteria must be undergoing constant —-
Catabolism
energy generation
anabolism
biosynthesis using energy
chemotrophs
organisms that get their energy from something other than sunlight like chemical reactions; gets carbon source from inorganic molecules or from the breakdown of food
autotrophs
a type of chemotroph that gets its carbon source from inorganic molecules like CO2 ,H2O; do not depend on another organism or chemical for their food, produce their own food
heterotroph
a type of chemotroph that gets its carbon source from the breakdown of food; requires organic material; can only break down food
chemoheterotrophs
MOST BACTERIA, especially most pathogens are classified as this (based on where their energy comes from and how they use it
Microbial requirements *= culture media
carbon, nitrogen, nonmetallic elements (S and P), metallic elements, vitamins, water, temperature*, pH of environment, atmospheric oxygen**
two ways the composition of a growth medium can be referred to as
Define and complex
Chemically defined media
These are composed of known quantities of chemically pure, specific organic and/or inorganic compounds. Their use requires knowledge of the organism’s specific nutritional needs
defined media aka
synthetic
what things can you find in synthetic/ defined media
carbon/ energy source
inorganic nitrogen (ammonium phosphate)
salta (NaCl, CaCl2, MgSO4)
growth factors specific to organism- amino acids, vitamins, etc.
complex media aka
undefined media
Complex Media
These are composed of a number of complex substances, plant and animal extracts, whose exact chemical compositions are not known. They can support the growth of most heterotrophs
a type of complex media
enriched media
Enriched media
a subset of complex media that allows for the cultivation of fastidious microorganisms, organisms that have highly elaborate and specific nutritional needs. These bacteria may not grow or grow poorly on basic artificial medium and require the addition of one or more growth-supporting substances such as additional plant or animal extracts, vitamins, or blood.
what can you find in complex (undefined media)
trypsin breakdown of proteins (peptone)
vitamins
carbohydrates (glucose)
salts/buffers
additional supplements (blood, milk, etc)
what are the types of complex media we use
nutrient broth/agar
tryptic soy broth/agar
lysogeny broth (LB)/ agar

components of media
Types of media
general growth media, selective (enrichment) media, differential media
general growth media, selective (enrichment) media, differential media
all of these can be either complex or defined
General growth media
non-specific media configured to culture a wide range of microorganisms without many restrictions
what are examples of general growth media
nutrient agar and luria- bertani (LB) broth
selective (enrichment) media
define
usage/purpose
example
one of the types of media
used to isolate microorganisms in a mixed culture, allows for the growth of particular microorganisms and restricts others using inhibitor components
Pseudomonas Isolation Agar (PIA)- isolate and cultivates Pseudomonas while restricting growth of most contaminating organisms
what role do bile salts, crystal violet and an antibiotic play in selective media?
allows it to inhibit growth of certain microorganisms
what are some growth inhibiting microorganisms found in selective media?
bile salts, crystal violet, and antibiotics
differential media
define
usage/purpose
example
a type of media
contains chemical compounds that cause observable change in the medium or the medium surrounding the bacteria when a specific reaction occurs, allowing you to decipher between cells; distinguishes microorganisms based on their morphology and biochemical processes
fermentation of sugars, pH indicators, blood agar
blood agar
a type of differential media that will
selective agents
inhibit/ prevent growth of undesired organisms; bile salts, high salt concentration, dyes, antibiotics
differential reagents
•Often pH indicator dyes
•The allows us to detect acidic/basic byproducts of metabolism when bacteria grow using specific substrates.
•These differences in metabolism are often unique to certain species of bacteria, and well-conserved among all isolates of a species.
•Different species of bacteria have adapted to prefer different food sources, and produce different byproducts. We can exploit these preferences!
why do media change color?
color change occurs when microorganisms metabolize a substrate (often a sugar), producing metabolic byproducts such as acids (ex: ferments lactose, produces lactic acid, acid lower pH, pH indicator dye changes color
Mannitol Salt Agar
Purpose
selective agent
differential agent
explain interpretations of it
used to test for the presence of Staphylococci
selective for Staphylococcus species; selective agent= High salt concentration (7.5%) NaCl; selective against non-staphylococci species like E.coli and other Gram negative bacteria (won’t grow because of the salt)
differential for Staph. aureus; mannitol is fermented by S. aureus and produces acid; phenol red is the pH indicator, which turns yellow, indicating mannitol fermentation (aka presence of S. aureus. other staph species like S. epidermidis can grow on mannitol salt agar, but will not show any yellow around it (doesn’t ferment the mannitol)
explain how mannitol fermentation relates to pH
when the mannitol is fermented (which it will be by S. aureus), it has a byproduct of acid, this acid causes the pH to lower, causing a change in the phenol red to change to yellow, once the pH is below 6.8
phenol red
what value is it red at? & what does it mean
what value is it yellow at? & what does it mean?
above 7.4 (meaning that there’s no mannitol fermentation, and therefore, no presence of staph. aureus
below 6.8 = positive for S. aureus
given the picture, give me the interpretations
top: S. aureus present (indicated by bacterial growth and yellow change in phenol red pH indicator)- mannitol fermentation took place, pH must be below 6.8- positive result
left: staph species present - growth, but phenol red= red; pH must be above 7.4
right: species other than staph (gram - specifically) here - no growth and phenol red= red because no acid production (aka no mannitol fermentation)- no result
Blood Agar
Purpose
differential agent
explain interpretations of it
used to differentiate bacteria based on hemolysis of red blood cells; tends to recover fastidious bacteria, often Streptococcus species NOT SELECTIVE
differential based on hemolysis of RBCs- is it sheep’s blood? and enriched (RBCs)- iron in Hb
green halo around bacterial species= alpha hemolysis (strep. pneumonaie); complete zone clearing(looks like its glowing) (strep. pyogenes); no clearing (looks very faint)= no color change= non-pathogenic bacteria
hemolytic pathogens (strep and staph)
what are fastidious bacteria
bacteria that require special nutrients or enriched media to grow
what is blood agar made of?/ what purpose does it serve?
blood agar is a trypic soy agar plate which is more general growth medium, but it contains whole sheep’s blood; this allows it to be differential for the ability of bacteria to lyse RBCs
what are the types of hemolysis
alpha hemolysis, beta hemolysis, and gamma hemolysis
partial/incomplete hemolysis, zone of partial clearing= green halo around bacterial colonies
alpha hemolysis (ex: Strep. pneumoniae)
green halo around bacterial colonies indicates what?
alpha hemolysis, can be strep. pneumoniae
complete hemolysis, complete zone of clearing around colonies
beta hemolysis; strep. pyogenes
what does beta hemolysis look like?
looks like a halo, huge zone of clearing around and below the colony
no lysis of RBC, no clearing of medium surrounding colonies, no color change
gamma hemolysis (non-pathogenic bacteria)
no hemolysis;
gamma hemolysis
what does gamma hemolysis look like?
no clearing of the medium surrounding the RBC, looks like normal bacterial growth, no crazy change

label them

explain what the following descriptions mean and what species could be residing there:
complete clearing zone around colony
partial clearing zone around colony- slightly green
no color change in media, surrounding media remains red
beta hemolysis (complete lysis of RBC) strep pyogenes
alpha hemolysis strep pneumoniae
gamma hemolysis (non-pathogenic bacteria
positive blood agar results
negative blood agar results
beta hemolysis (complete clearing)
gamma hemolysis (no clearing - little to no change)
label them
beta, alpha, and gamma hemolysis, respectively
MacConkey Agar
Purpose
selective agent
differential agent
explain interpretations of it
selective for gram - bacteria (enterobacteriaecae) and differentiates lactose fermenters vs. non-lactose fermenters***
selective for gram negative enteric bacteria (enterobacteriaceae); selective agents; selective agent= crystal violet and bile salts, inhibits G+
differential for coliforms (lactose fermenters) vs. non-coliforms (non-lactose fermenters); differential agent= neutral red indicator and lactose
neutral red indicator and lactose
what are they
explain what they look like? what does this indicate?
they’re the differential agents for MacConkey Agar
neutral red indicator: if pH is above 6.8= colorless (non-coliforms ; if above 6.8= RED/Pink (coliforms)
what is a coliform?
a coliform is a rod-shaped gram -, non-spore forming bacteria which can ferment lactose with the production of acid and gas when incubated at 35-37C; typically colon bacteria
a rod-shaped gram -, non-spore forming bacteria which can ferment lactose with the production of acid and gas when incubated at 35-37C; typically colon bacteria
coliform
bacteria that do not ferment lactose
non-coliform bacteria
non-coliform bacteria
bacteria that do not ferment lactose
how are bile salts and crystal violet selective against G+ bacteria
they don’t have the outer membrane to protect the cell wall (like gram -) bacteria
examples of coliform bacteria
Escherichia, Klebsiella, Serratia
Escherichia, Klebsiella, Serratia are examples of what
coliform bacteria
Salmonella, Shigella, and Yersinia
examples of non-coliform bacteria
Salmonella, Shigella, and Yersinia are all examples of what?
non-coliform bacteria; note that these are still gram - bacteria, so they do still grow on MacConkey Agar
what is the original color of MacConkey Agar
very light pink/ almost light orange looking

explain the picture using technical terms
what this showing (what type of agar)
explain whats happening on the right and what it can be
explain what’s happening on the left and what it can be
MacConkey Agar
non-lactose fermenting colonies, no lactic acid formation, pH is above 6.8, so indicator dye is colorless= light orange-ish color; Salmonella, Shigella, or Yersinia
lactose fermenting colonies, lactic acid byproduct—> everything turns light pink; E.coli, Klebsiella, Serratia
describe the following, provide the mechanism behind it, and give an example of what type of organism it can be:
Positive result for MacConkey agar
Negative Result for MacConkey agar
red/pink color, coliform aka lactose fermenters are present,
light orange/ colorless, non-coliform, non-lactose fermenters present